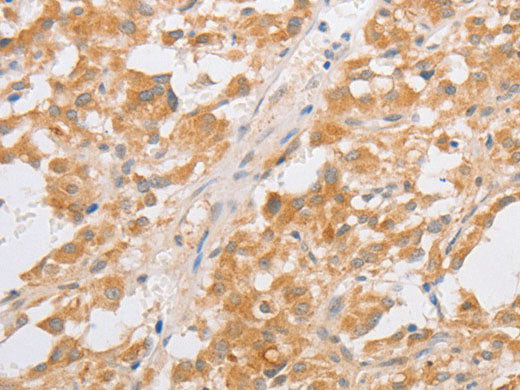
CDKN2AIP Polyclonal Antibody Store at -20°C

CDKN2AIP Polyclonal Antibody Store at -20°C
Couldn't load pickup availability

Still have questions? Ask our experts!
CDKN2AIP Polyclonal Antibody Store at -20°C
| SKU # | E-AB-10510 |
| Reactivity | Human |
| Host | Rabbit |
| Applications | IHC |
Product Details
| Isotype | IgG |
| Host | Rabbit |
| Reactivity | Human |
| Applications | IHC |
| Clonality | Polyclonal |
| Immunogen | Recombinant protein of human CDKN2AIP |
| Abbre | CDKN2AIP |
| Synonyms | CARF, CDKN2A interacting protein, CDKN2A-interacting protein, Calcium response factor, Cdkn2aip, Collaborator of ARF, FLJ20036, collaborates/cooperates with ARF (alternate reading frame) protein |
| Swissprot | |
| Cellular Localization | Nucleus>nucleoplasm. |
| Concentration | 0.3 mg/mL |
| Buffer | Phosphate buffered solution, pH 7.4, containing 0.05% stabilizer and 50% glycerol. |
| Purification Method | Affinity purification |
| Research Areas | Cancer, Cell Biology, Epigenetics and Nuclear Signaling |
| Conjugation | Unconjugated |
| Storage | Store at -20°C Valid for 12 months. Avoid freeze / thaw cycles. |
| Shipping | The product is shipped with ice pack,upon receipt,store it immediately at the temperature recommended. |
Related Reagents
| Applications | Recommended Dilution |
| IHC | 1:50-1:200 |
Background
CDKN2AIP (CDKN2A-interacting protein), also known as CARF, is a 580 amino acid protein that activates p53 via p14 ARF (alternate reading frame)-dependent and independent pathways. CDKN2AIP-dependent activation of p53, a protein that up-regulates growth arrest and apoptosis-related genes in response to stress signals, leads to an enhancement of p53 function. Expression levels of CDKN2AIP and p53 show an inverse relationship that is caused by a negative-feedback control via a proteasome-mediated degradation pathway. CDKN2AIP is expressed ubiquitously across tissue samples and, along with p14 ARF, is localized to the perinucleolar region within the nucleus.